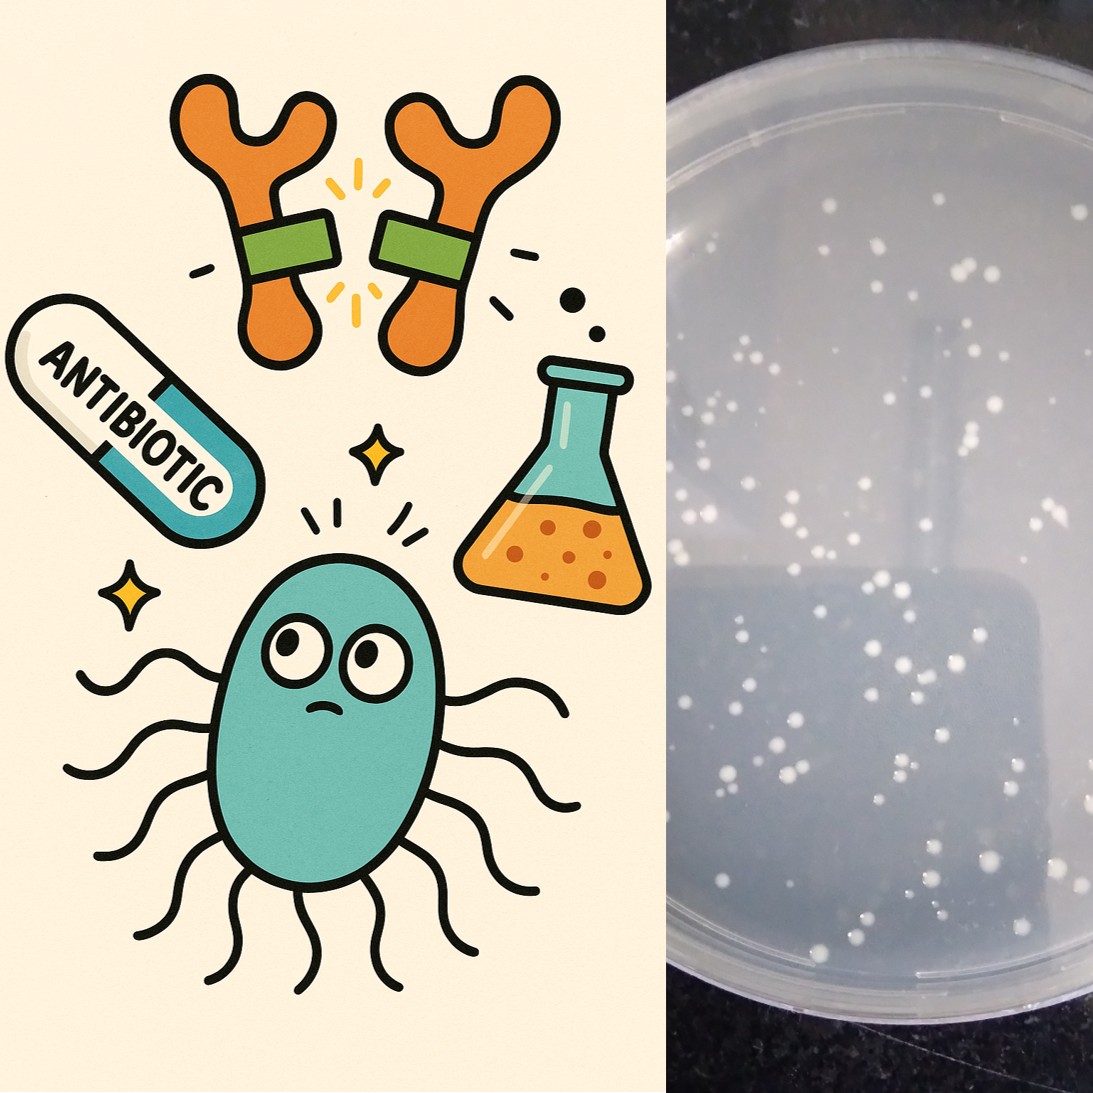

PiBook Bio: Engineered Data for Engineered Biology
Custom Protein Data & Engineering Services. Tailored. Scalable. Impactful. PiBook empowers biotech with AI-scale experimental datasets, outcome-driven protein engineering campaigns, and rapid binary protein complex structure discovery.

What We Offer
Explore our services that elevate your biotech research and development to the next level.
Comprehensive Data to Train Protein Design AI
We generate vast amounts of experimentally verified data for Protein-Protein and Protease-Substrate Interactions. Our advanced integration of multiple assays ensures accuracy and reliability, making our data perfect for machine learning applications.

Tailored Protein Engineering Solutions for You
Our protein engineering campaigns are designed to enhance affinity and specificity for protein-protein interactions. We focus on protease redesign to create novel substrate specificity, ensuring impactful results for your research.
Outcome-Driven
Achieve the highest quality results with our expert-driven experimental campaigns.
Innovative Design
We optimize every aspect for superior research outcomes.

Accelerated Structure Determination for Protein Complexes at Unmatched Speed
Our service provides rapid and accurate structures of binary protein complexes, even for those that are weakly bound. This innovative approach supports structural validation and enhances AI training with experimental data.
Speedy Solutions
Faster results for structural validation of engineered protein variants.
Innovative Approach
Experimental data enhances AI training and predictive modeling capabilities.

Technology Platforms
Explore our state-of-the-art platforms designed for cutting-edge protein engineering and data solutions.
Phage Display: Unleashing the Power of Antibody Variant Screening
Our Phage Display technology screens billions of antibody and other desired protein variants simultaneously, ensuring rapid identification of high-affinity binders. This iterative selection process optimizes specificity and affinity for your unique applications.
Key Specs
Library size: 10⁸–10⁹, Platform: M13 phage in E. coli
Output
High-confidence variant tables, ready for engineering or training

Interaction Strength, Measured by Survival
Our in vivo protein-fragment complementation system in E. coli utilizes antibiotic resistance as a direct measure of binding strength. This method is ideal for efficiently mapping and ranking protein-protein interactions at scale.
Real-Time Protein Interaction Sensing
Our Fluorescence-Based PCA utilizes a split-fluorescence system that reconstitutes upon the binding of variant fragments. This innovative approach allows for real-time, dynamic readouts of weak or transient protein interactions, providing more than just binary data. With quantified PPI signal curves, this platform is ideal for validation processes and AI tuning.

Selection-Driven Discovery of Optimal Cleavage
Our Protease Evolution Systems utilize two innovative selection methods to evolve proteases and identify novel substrate motifs. These systems are guided by antibiotic-based survival pressure, ensuring optimal cleavage discovery.
Library size: 10⁸–10⁹
Platform: Positive/negative selection in bacteria
Readout: Functional cleavage via growth

Binary Complex Structure Platforms: Accelerated Insights for AI-Driven Discoveries
Our advanced platforms provide rapid structural insights into weak and transient binary complexes, seamlessly integrating with X-ray and Cryo-EM technologies. This ensures that your data-driven decisions are grounded in atomic-resolution models and contact maps, enhancing validation and optimization efforts.

Why Choose PiBook
Discover the advantages of partnering with PiBook for your protein engineering and data needs.

Data Built for AI
At PiBook Bio, we provide unparalleled data solutions tailored for AI applications. Our commitment to quality ensures that every dataset is structured, annotated, and ready for predictive modeling.

Scalable Platforms: Optimized for Thousands to Billions of Variants with Precision
Our scalable platforms are designed to efficiently manage a vast range of variants, from thousands to billions. This ensures that we maintain biological accuracy while delivering high-quality results.
Optimized for high-throughput protein engineering workflows.
Ensuring accuracy without sacrificing speed or efficiency.
Delivering reliable results for diverse biological applications.

Multi-System Validation: Ensuring Accuracy Through Independent Assay Confirmation
Our commitment to precision means that every discovery is rigorously validated. By employing independent orthogonal assays, we ensure that our findings are reliable and reproducible.

Complete Solutions for Protein Engineering Success
Our end-to-end protein engineering services streamline the entire process from variant design to validation. We ensure that every step is meticulously executed for optimal results.
Transforming ideas into validated protein solutions efficiently.
Delivering precision and reliability in protein engineering.
Your partner in innovative protein engineering solutions.

Accelerate Your Research with Structural Insights
PiBook’s structural platforms deliver binary complex structures significantly faster than conventional methods. This speed allows for informed, data-driven decisions and provides AI-ready insights for your projects.
Transforming data into actionable insights quickly.
Empowering your research with rapid structural data.

Our Team
Dedicated professionals driving innovation in protein engineering.

Expert in wet-lab platforms & protein structure research, with 20+ years of experience. Leads PiBook Bio’s experimental operations and assay development.

AI specialist, with 20+ years of active research experience, driving data strategy and computational integration across PiBook Bio.
Contact Us
We'd love to hear from you!